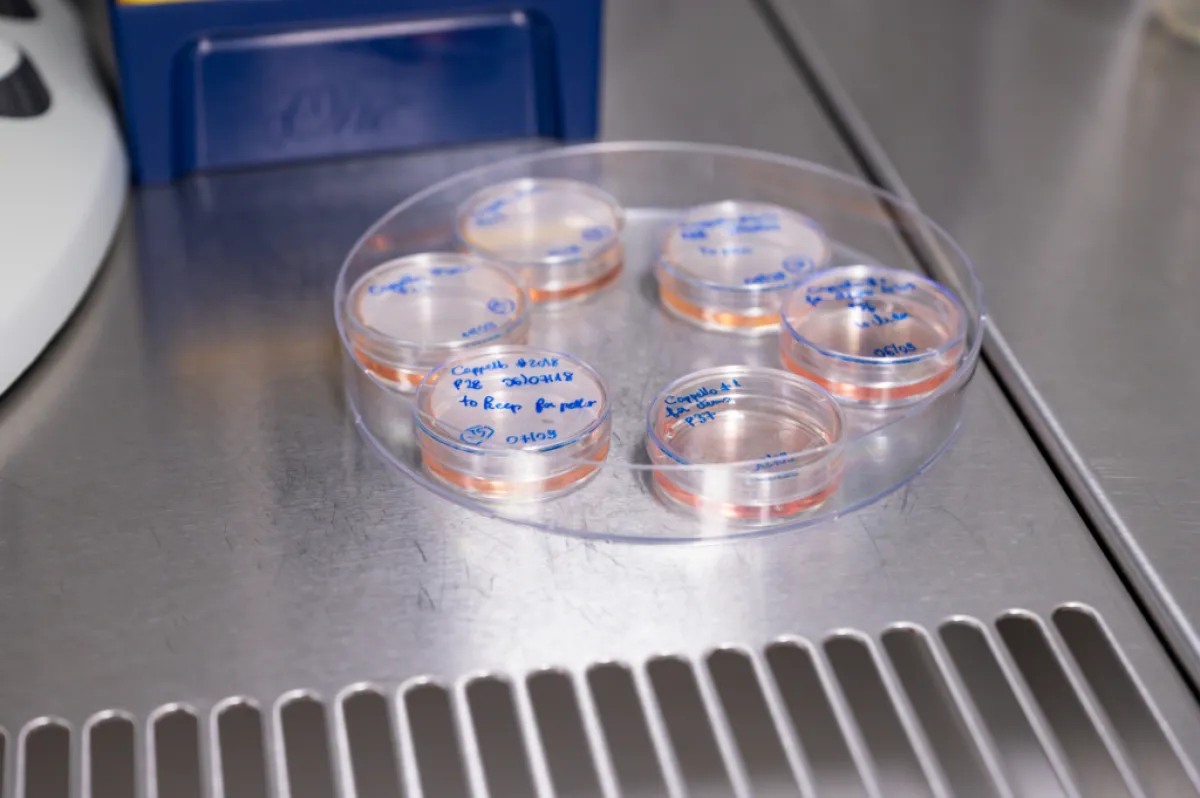

Alexandre Baffet Le fabuleux destin des cellules souches du cortex cérébral
Chargé de recherche Inserm, Chef de l’équipe « Biologie cellulaire de la neurogenèse des mammifères » à l’Institut Curie, Paris.
- 2023 • Impulscience

Le cortex cérébral humain est connu pour sa complexité et sa grande taille qui sont clés pour le développement de fonctions spécifiques à l’Homme, comme le langage. L’ambition d’Alexandre Baffet est de comprendre une part de cette complexité unique, celle qui provient des décisions prises par les cellules souches neurales afin de générer la grande diversité de cellules nécessaires au bon fonctionnement du cortex. Les techniques de microscopie qu’il développe avec son équipe de recherche seront des alliées précieuses pour relever ce défi.
Le cortex cérébral fait preuve d’une grande diversité cellulaire
Le cortex cérébral est la partie la plus superficielle de notre cerveau, et aussi l’une des plus complexes. Il est composé d’une grande diversité de types cellulaires, dont plusieurs sortes de neurones inhibiteurs et excitateurs ainsi que les cellules gliales (astrocytes et oligodendrocytes, qui aident les neurones à réaliser leur fonctions). La majorité de ces cellules est générée, au cours du développement embryonnaire, par les cellules souches neurales. Ces cellules, particulièrement abondantes chez l’humain, peuvent en effet entreprendre plusieurs choix de destin quand elles se divisent pour générer de nouvelles cellules : générer des cellules souches neurales, générer un type particulier de neurone ou générer une cellule gliale particulière. Ces choix peuvent varier entre les espèces, ainsi qu’au cours du temps et en fonction de la position des cellules dans le tissu (plus ou moins profondément dans le cortex). Cependant, la manière dont cette diversité apparaît au cours du développement, et sous-tend les différences de compostions cellulaires entre les différents primates, n’est pas encore comprise.
Comprendre la source de la diversité
Pour comprendre comment les choix effectués lors de la division des cellules souches neurales ont impacté la complexité et l’évolution du cortex cérébral des primates, il est nécessaire de pouvoir décortiquer la nature de ces choix, en les identifiant dans le temps et l’espace.
Alexandre Baffet et son équipe à l’Institut Curie proposent de cartographier ces profils de divisions des cellules souches neurales grâce à des méthodes d’imagerie en temps réel. Pour ce faire, ils utiliseront une technique qu’ils ont mis au point récemment et qui permet filmer les cellules souches neurales en division au sein du tissus durant plusieurs jours, puis d’identifier les types de cellules produites. Ils chercheront à comprendre l’effet du milieu (ou microenvironnement) dans lequel évoluent ces cellules sur leurs décisions de destin, et de comprendre les variations au sein de l’ordre des primates.
Des modèles pour répondre à de grandes questions de l’évolution
L’équipe utilise ainsi des modèles dit d’organoïdes, qui récréent certaines caractéristiques du cortex cérébral humain in vitro. La dotation Impulscience® lui permettra de développer des méthodes d’imagerie poussées de ces tissues, afin de mesurer précisément les décisions prises par les cellules souches neurales, et de comprendre comment l’environnement des cellules influence leur destin. De plus, en comparant ces caractéristiques avec celles qu’ils observeront dans des organoïdes de chimpanzés, l’espèce la plus proche à l’Homme, il sera possible d’identifier les caractéristiques spécifiques à l'Homme qui sous-tendent la composition cellulaire et la taille de notre cortex cérébral.
Alexandre Baffet tient également à mettre en avant les techniques utilisées dans son laboratoire pour qu’elles soient utilisées par d’autres équipes de recherche. Dans ce contexte, il développe actuellement des approches pour comprendre comment des déraillements dans les décisions de destin des cellules souches neurales peuvent mener à des tumeurs cérébrales pédiatriques.
Alexandre Baffet en quelques mots
Filmer les tissus « en direct » pour comprendre la dynamique de leur formation est au cœur de la carrière d’Alexandre Baffet. Il a développé cette expertise depuis son doctorat obtenu en 2010 à l’Institut Jacques Monod et à l’Université Paris VI, au cours duquel il a étudié le transport de molécules dans la chambre ovarienne de la mouche drosophile. Pendant son séjour post-doctoral à l’université de Columbia aux États-Unis, il s’est intéressé au développement du cerveau et, toujours en utilisant l'imagerie en direct, il a étudié la migration des cellules souches neurales dans le cortex chez les rongeurs.
Depuis la création de son équipe de recherche à l’Institut Curie en 2016, il repousse les limites de l'imagerie en direct du tissu cérébral pour étudier le développement du cortex.

Programme Impulscience
Impulscience attribue chaque année 7 nouveaux soutiens à des chercheuses et chercheurs en sciences de la vie. Concentré sur le milieu de carrière, ce programme a pour objectif de soutenir cette étape cruciale pour le développement des projets de recherche.
Tous les lauréats du prixAppel à candidatures
L'appel à candidatures est ouvert du 7 avril 2026 au 21 mai 2026 pour les candidats ayant répondu aux appels à projet ERC Starting et Consolidator 2025 ; et jusqu'au 22 juin 2026 pour les candidats ayant répondu à l'appel à projet ERC Advanced 2025.